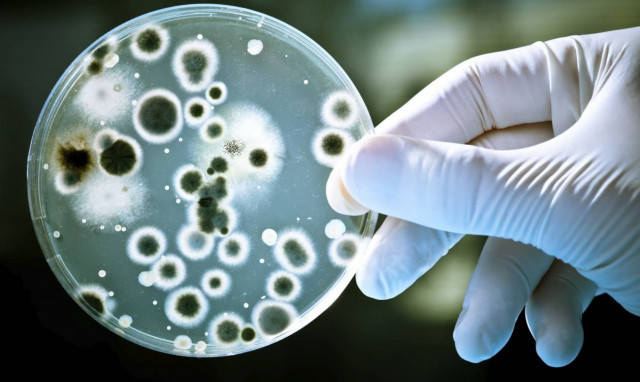
Σε αυτή την ηλεκτρική συσκευή του σπιτιού σας κάνουν... πάρτι βακτήρια και μύκητες

ΜΥΚΗΤΕΣ

Πώς οι μύκητες μπορούν να επηρεάσουν τον καιρό και να προκαλέσουν βροχή
WHAT THE FACT
·
28.04.2026 - 23:00
Οι επιστήμονες ανακάλυψαν το «μυστικό» πίσω από αυτή τη διαδικασία

Γιατί δεν πρέπει να αφήνετε το πλυντήριο ρούχων ανοιχτό - Αυτός είναι ο λόγος
WHAT THE FACT
·
26.07.2025 - 09:39
Οι περισσότεροι πιστεύουν ότι με αυτόν τον τρόπο ότι θα φύγει η υγρασία και να μην «μείνουν» δυσάρεστες οσμές

Εξαπλώνεται o θανατηφόρος μύκητας «Aspergillus» που «θρέφεται» από την κλιματική αλλαγή: Πόσο μας απειλεί και πώς συνδέεται με τη σειρά «Τhe Last of Us»
ΚΟΣΜΟΣ
·
26.05.2025 - 12:53
Οι μύκητες που προκαλούν λοιμώξεις και ευθύνονται για εκατομμύρια θανάτους ετησίως θα εξαπλωθούν σημαντικά σε νέες περιοχές καθώς ο πλανήτης θερμαίνεται, προειδοποιεί νέα έρευνα. Ο…

Τι μπορούν να αποκαλύψουν τα νύχια για την υγεία μας - «Καθρέφτης» για προβλήματα και παθήσεις
ΚΟΣΜΟΣ
·
10.02.2025 - 12:51
Τα νύχια βοηθούν στην προστασία του υποκείμενου δέρματος από τραυματισμό και είναι επίσης χρήσιμα όταν έχουμε...φαγούρα. Τι αποκαλύπτουν όμως για την υγεία μας; Το BBC…

Επιστήμονες ανακάλυψαν «κρυφή επιδημία» μυκήτων που ελέγχουν το μυαλό και μετατρέπουν τις αράχνες σε πραγματικά ζόμπι
ΚΟΣΜΟΣ
·
05.02.2025 - 11:46
Βαθιά μέσα στις υγρές σπηλιές της Βόρειας Ιρλανδίας, οι επιστήμονες ανακάλυψαν αράχνες παγωμένες στη θέση τους, καλυμμένες με έναν ασυνήθιστο μύκητα

Οι επιστήμονες έχουν ανακαλύψει περίπου το 10% όλων των ειδών στη Γη - Τι βρήκαν το 2024
ΚΟΣΜΟΣ
·
05.01.2025 - 14:43
Από νυχτοπεταλούδες μέχρι και ορχιδέες αυτά είναι μερικά από τα νέα είδη που ανακάλυψαν οι επιστήμονες το 2024

Σαγιονάρες: Πότε γίνονται αιτία μολύνσεων και τι μπορούμε να κάνουμε
ΥΓΕΙΑ
·
06.08.2024 - 07:14
Οι σαγιονάρες ενδέχεται να γίνουν αιτία μολύνσεων στο δέρμα και στα νύχια, εάν δεν ακολουθούνται κάποιοι βασικοί κανόνες.

Δερματοπάθειες, ο εφιάλτης του καλοκαιριού - Πώς να τις αντιμετωπίσετε
ΥΓΕΙΑ
·
30.07.2024 - 12:01
Οδηγός αντιμετώπισης για τις καλοκαιρινές δερματοπάθειες που ταλαιπωρούν πολλούς ανθρώπους κάθε χρόνο

Η επόμενη πανδημία μπορεί να εκραγεί από θανατηφόρο μύκητα
ΚΟΣΜΟΣ
·
01.05.2024 - 14:29
Κύμα λοιμώξεων από μύκητες που σταματούν την αναπνοή των ανθρώπων και προκαλούν διόγκωση του εγκεφάλου

Αυτά που κρύβονται στο νεροχύτη σας είναι επικίνδυνα -Τι έδειξε έρευνα
ΚΟΣΜΟΣ
·
25.12.2022 - 16:28
Ερευνητές του University of Reading μελέτησαν αυτό το υγρό οικοσύστημα και βρήκαν πάνω από 250 κοινότητες μυκήτων να ευδοκιμούν στους νεροχύτες του Πανεπιστημίου.

Απίστευτο: Δείτε τι προκάλεσε ένας μύκητας στα Ιωάννινα
ΕΛΛΑΔΑ
·
26.10.2020 - 10:31
Στην παλιά εθνική οδό Ιωαννίνων -Άρτας, η περιοχή μετά το Τέροβο, λέγεται Πλατανάκια. Ο λόγος προφανής.

Έτσι θα προφυλαχθείτε από τους μύκητες σε θάλασσα και πισίνα
WHAT THE FACT
·
17.06.2018 - 14:00
Οι μυκητιάσεις από την θάλασσα στα πόδια και τα γεννητικά όργανα αλλά και οι λοιμώξεις του ουροποιητικού συστήματος είναι πολύ συχνές το καλοκαίρι ειδικά στις…
Σε αυτή την ηλεκτρική συσκευή του σπιτιού σας κάνουν... πάρτι βακτήρια και μύκητες
WHAT THE FACT
·
15.01.2018 - 11:18
Δουλειά του είναι να καθαρίζει αλλά...

Μύκητες στα πόδια: Τι να προσέξετε για να τους αποφύγετε
ΥΓΕΙΑ
·
23.06.2016 - 22:56
Οι μύκητες των ποδιών αναπτύσσονται συνήθως μεταξύ των δαχτύλων ή στα νύχια και είναι γνωστοί και ως «πόδι του αθλητή».

ΠΡΟΣΟΧΗ: Ανάκληση κέικ με φράουλα - Έχουν αναπτυχθεί μύκητες
ΕΛΛΑΔΑ
·
11.03.2014 - 17:30
Εντολή για ανάκληση παρτίδας τυποποιημένου κέικ με γέμιση φράουλας έδωσε ο ΕΦΕΤ, αφού διαπίστωσε πως στο εσωτερικό τμήμα του προϊόντος είχαν αναπτυχθεί μύκητες, παράλληλα με…

Οι μύκητες αγαπούν τα πόδια των ανθρώπων!
ΥΓΕΙΑ
·
23.05.2013 - 09:58
Σχεδόν 200 διαφορετικά είδη μυκήτων έχουν κάνει «σπίτι» τους τα πόδια κάθε ανθρώπου, όπως δείχνει ο πρώτος γενετικός «χάρτης» των ποικίλων ειδών μυκήτων που ζουν…

Εντοπίστηκαν μύκητες σε φυσικό χύμο
ΕΛΛΑΔΑ
·
23.11.2011 - 17:33
Την απόσυρση παρτίδας φυσικού χυμού με την επωνυμία ΟΛΥΜΠΟΣ 100% Ελληνικός Φυσικός Χυμός, μήλο, πορτοκάλι, καρότο», διέταξε ο Ε.Φ.Ε.Τ., ύστερα από καταγγελία για ύπαρξη μυκήτων…






